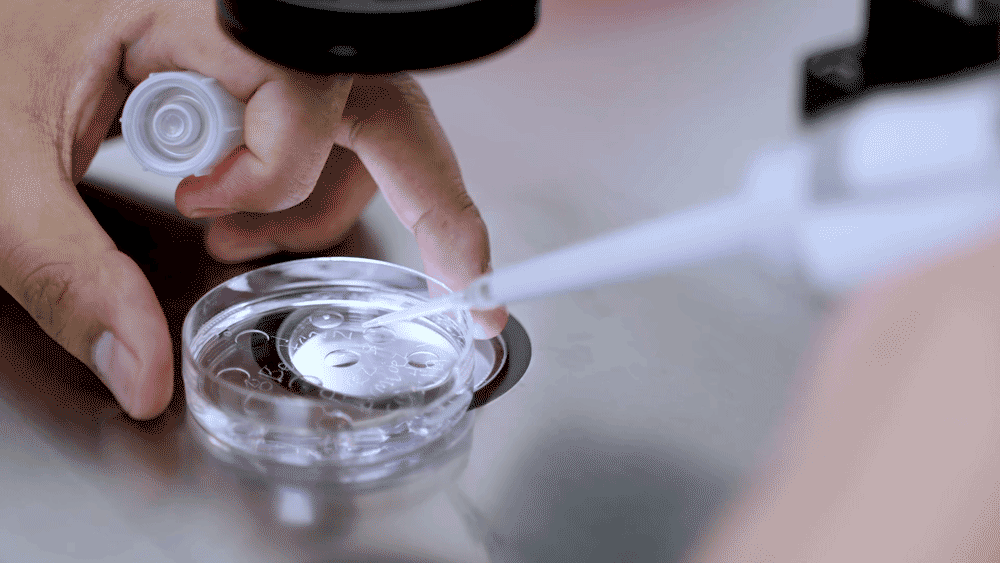
embryo-factor-infertility-fertility-assisted-reproduction

El factor embrionario es un aspecto crucial de la fertilidad, pero a menudo se pasa por alto en las discusiones sobre la concepción. Un embrión consta de 46 cromosomas, 23 de la madre y 23 del padre. Cualquier problema genético dentro de estos cromosomas podría potencialmente impedir que un embarazo llegue a término, evitando finalmente la alegría de traer un bebé a casa.
Cuando un óvulo es fecundado por un espermatozoide, cada progenitor aporta estos 23 cromosomas, cada uno conteniendo un número específico de genes. Estos genes formarán finalmente el embrión. Sin embargo, si hay alguna anormalidad genética en los cromosomas de cualquiera de los progenitores, o si el embrión presenta alguna perturbación en sus cromosomas, esto podría desencadenar problemas como fallos de implantación e incluso abortos recurrentes.

¿Cuáles son las causas asociadas con el factor embrionario de infertilidad?
- Fallo de implantación: Se determina cuando no ocurre un embarazo después de tres ciclos de Fecundación In Vitro (FIV).
- Alteraciones genéticas: Son problemas en genes o cromosomas que impiden que el embrión se desarrolle adecuadamente.
- Aborto recurrente: Se refiere a la pérdida de dos o más embarazos consecutivos antes de la semana 20.
Pero aquí está la noticia alentadora: incluso con la presencia de un factor embrionario, tener un bebé es aún posible. Cualquier condición genética o problema que tú, tu pareja o tu embrión puedan estar experimentando puede ser abordado adecuadamente. No es un obstáculo para que lleves a cabo un embarazo con éxito y des la bienvenida a un bebé en tu vida.

Busca ayuda profesional
Si no has logrado tener un bebé debido a algún factor embrionario, recuerda – no estás sola. El primer paso para superar este obstáculo es nuestro Programa Inicial, dirigido por especialistas en reproducción asistida. Nuestro equipo dedicado está comprometido a cumplir tu deseo más profundo – convertirte en madre.
Creemos que la información es empoderadora. Al entender el rol del factor embrionario, puedes tomar decisiones informadas sobre tu fertilidad y los pasos necesarios para alcanzar tu objetivo. Puede ser un viaje desafiante, pero recuerda: eres más fuerte de lo que piensas, y con el apoyo adecuado, tus sueños de ser madre pueden convertirse en realidad.